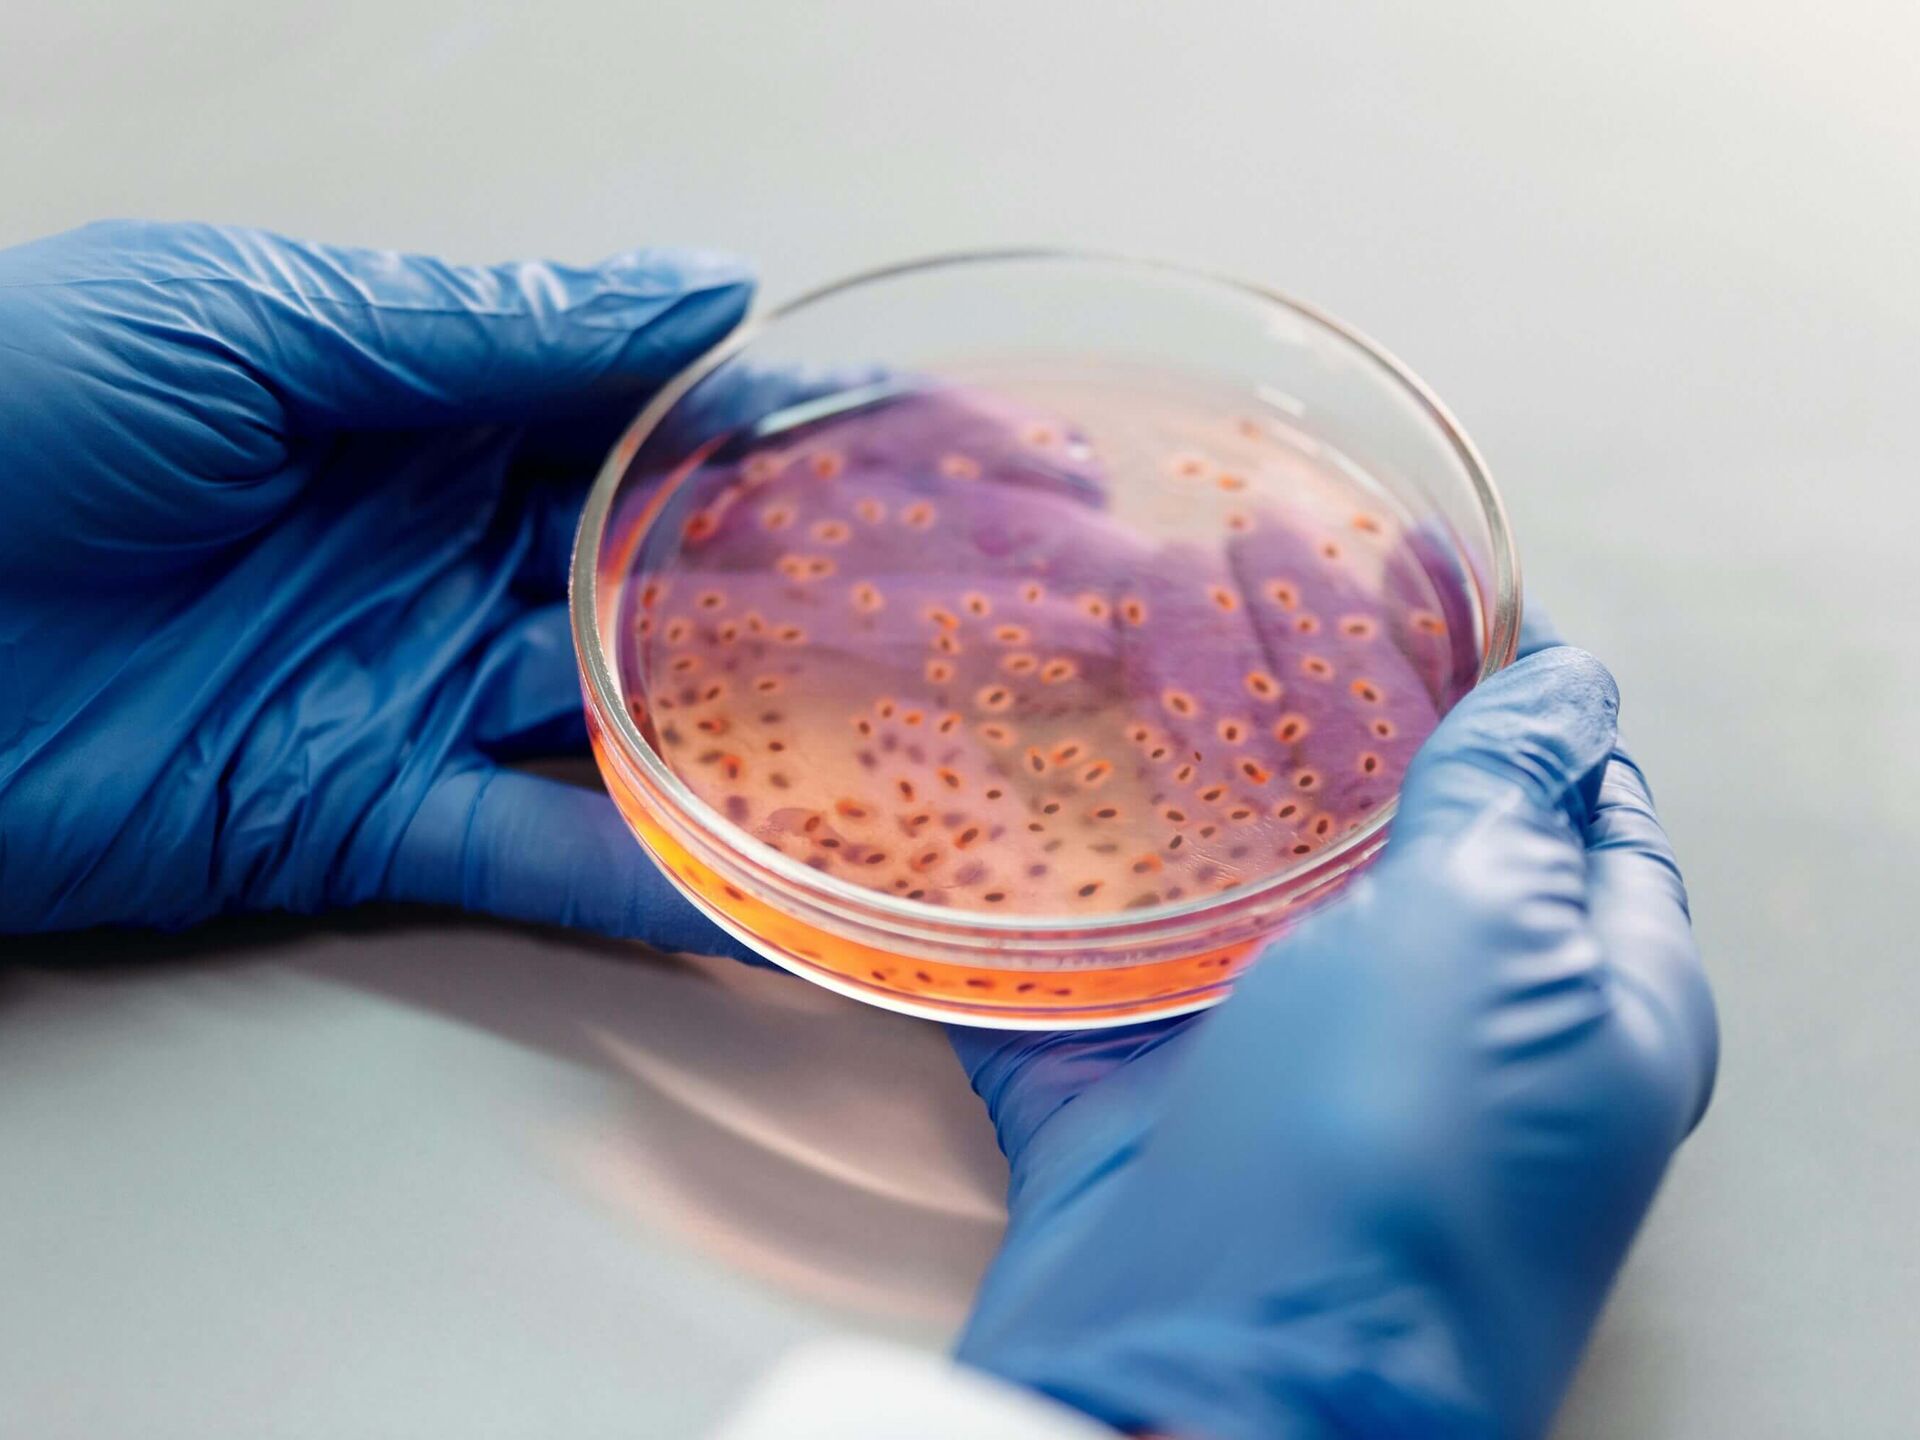

Master
Fakultät Gesundheit und Sport
Die Fakultät Gesundheit & Sport bietet neben den universitären Studiengängen Psychotherapie (M.Sc.) und Medizinpädagogik (M.Ed./M.A.) auch den anwendungsorientierten den Studiengang Sportwissenschaften Athletiktrainer:in im Fußball (M.Sc.) mit Fachhochschulstatus am Standort Düsseldorf/Krefeld an. Alle Studiengänge der Fakultät Gesundheit & Sport sind fachlich durch die AHPGS akkreditiert bzw. sind zurzeit im Akkreditierungsverfahren.
Fakultät Medizin
Die Fakultät Medizin bietet neben dem universitären Staatsexamensstudiengang auch den anwendungsorientierten den Studiengang Biomedizin (M.Sc.) mit Fachhochschulstatus an. Alle Studiengänge der Fakultät Medizin sind fachlich durch die AHPGS akkreditiert bzw. sind zurzeit im Akkreditierungsverfahren.
Campus Düsseldorf/Krefeld
Am Campus Düsseldorf/Krefeld bieten wir den fachhochschulischen Masterstudiengang Sportwissenschaften Athletiktrainer:in im Fußball (M.Sc.) an. Im Zentrum des Masters steht die gezielte Weiterentwicklung athletischer Leistungsfähigkeit – durch evidenzbasierte Trainingskonzepte, moderne
Leistungsdiagnostik und ein interdisziplinäres Verständnis sportlicher Belastung im Team- und Individualtraining.